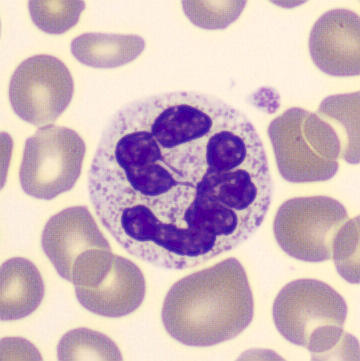
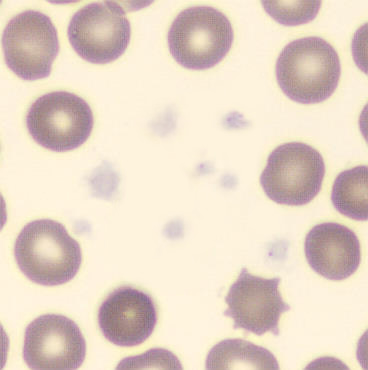

Fibrin strands
When the clotting cascade is activated before, during or after blood sampling, gray/white threads may be seen in the smear; fibrin strands. Because clotting has occurred, a falsely decreased number of platelets and highly abnormal morphology may be present.